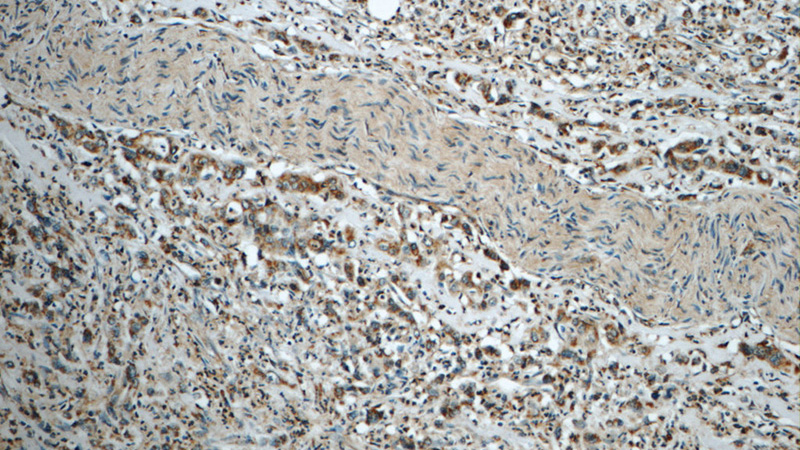
Immunohistochemistry of paraffin-embedded human stomach cancer tissue slide using Catalog No:116139(TIMP1 Antibody) at dilution of 1:50 (under 10x lens)
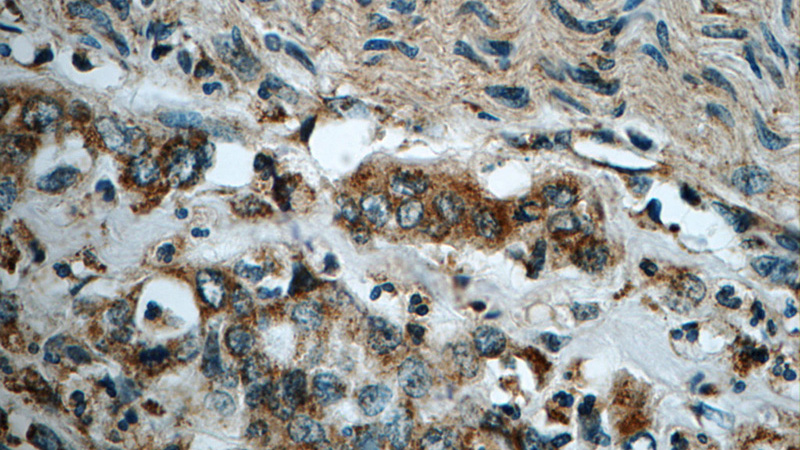
Immunohistochemistry of paraffin-embedded human stomach cancer tissue slide using Catalog No:116139(TIMP1 Antibody) at dilution of 1:50 (under 40x lens)

-
Product Name
TIMP1 antibody
- Documents
-
Description
TIMP1 Rabbit Polyclonal antibody. Positive IF detected in BxPC-3 cells. Positive IHC detected in human stomach cancer tissue, human pancreas tissue, human thyroid cancer tissue.
-
Tested applications
ELISA, IHC, IF
-
Species reactivity
Human, Mouse; other species not tested.
-
Alternative names
CLGI antibody; Collagenase inhibitor antibody; EPA antibody; EPO antibody; FLJ90373 antibody; HCI antibody; Metalloproteinase inhibitor 1 antibody; TIMP antibody; TIMP 1 antibody; TIMP1 antibody; TIMP-1 antibody
-
Isotype
Rabbit IgG
-
Preparation
This antibody was obtained by immunization of TIMP1 recombinant protein (Accession Number: BC007097). Purification method: Antigen affinity purified.
-
Clonality
Polyclonal
-
Formulation
PBS with 0.1% sodium azide and 50% glycerol pH 7.3.
-
Storage instructions
Store at -20℃. DO NOT ALIQUOT
-
Applications
Recommended Dilution:
IHC: 1:20-1:200
IF: 1:10-1:100
-
Validations
Immunohistochemistry of paraffin-embedded human stomach cancer tissue slide using Catalog No:116139(TIMP1 Antibody) at dilution of 1:50 (under 10x lens)
Immunohistochemistry of paraffin-embedded human stomach cancer tissue slide using Catalog No:116139(TIMP1 Antibody) at dilution of 1:50 (under 40x lens)

Immunofluorescent analysis of BxPC-3 cells using Catalog No:116139(TIMP1 Antibody) at dilution of 1:25 and Alexa Fluor 488-congugated AffiniPure Goat Anti-Rabbit IgG(H+L)
-
Background
TIMP1 represents TIMP metallopeptidase inhibitor 1
-
References
- He S, He Z, Chen Y. C-Kit/c-Kit ligand interaction of bone marrow endothelial progenitor cells is influenced in a cigarette smoke extract-induced emphysema model. Experimental lung research. 39(6):258-67. 2013.
- Shen M, Chen K, Lu J. Protective effect of astaxanthin on liver fibrosis through modulation of TGF-β1 expression and autophagy. Mediators of inflammation. 2014:954502. 2014.
- Lin JJ, Su JH, Tsai CC, Chen YJ, Liao MH, Wu YJ. 11-epi-Sinulariolide acetate reduces cell migration and invasion of human hepatocellular carcinoma by reducing the activation of ERK1/2, p38MAPK and FAK/PI3K/AKT/mTOR signaling pathways. Marine drugs. 12(9):4783-98. 2014.
- Xu J, Wang P, Wang T. Effects of reduced β2-glycoprotein I on the expression of aortic matrix metalloproteinases and tissue inhibitor matrix metalloproteinases in diabetic mice. BMC cardiovascular disorders. 14:114. 2014.
- Shang L, Liu HJ, Hao JJ. A panel of overexpressed proteins for prognosis in esophageal squamous cell carcinoma. PloS one. 9(10):e111045. 2014.
- Fa KN, Yang CM, Chen PC, Lee YY, Chyau CC, Hu ML. Anti-metastatic effects of antrodan, the Antrodia cinnamomea mycelia glycoprotein, in lung carcinoma cells. International journal of biological macromolecules. 74:476-82. 2015.
- Xie Y, Cui D, Sui L. Induction of forkhead box M1 (FoxM1) by EGF through ERK signaling pathway promotes trophoblast cell invasion. Cell and tissue research. 362(2):421-30. 2015.
- Dong D, Yin L, Qi Y, Xu L, Peng J. Protective Effect of the Total Saponins from Rosa laevigata Michx Fruit against Carbon Tetrachloride-Induced Liver Fibrosis in Rats. Nutrients. 7(6):4829-50. 2015.
Related Products / Services
Please note: All products are "FOR RESEARCH USE ONLY AND ARE NOT INTENDED FOR DIAGNOSTIC OR THERAPEUTIC USE"
